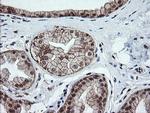
OTUB1 Antibody in Immunohistochemistry (Paraffin) (IHC (P))

Search
OriGene
OTUB1 Monoclonal Antibody (OTI2H1), TrueMAB™
{{$productOrderCtrl.translations['antibody.pdp.commerceCard.promotion.promotions']}}
{{$productOrderCtrl.translations['antibody.pdp.commerceCard.promotion.viewpromo']}}
{{$productOrderCtrl.translations['antibody.pdp.commerceCard.promotion.promocode']}}: {{promo.promoCode}} {{promo.promoTitle}} {{promo.promoDescription}}. {{$productOrderCtrl.translations['antibody.pdp.commerceCard.promotion.learnmore']}}
产品信息
CF505158
宿主/亚型
分类
类型
克隆号
抗原
偶联物
形式
浓度
规格
保存条件
运输条件
产品详细信息
For reconstitution, we recommend adding 100 µL distilled water to a final antibody concentration of about 1 mg/mL. To use this carrier-free antibody for conjugation experiments, we strongly recommend performing another round of desalting. (Zeba Spin Desalting Columns, 7KMWCO, 0.5 mL, Product # 89882)
靶标信息
The product of this gene is a member of the OTU superfamily of predicted cysteine proteases. The encoded protein is a highly specific ubiquitin iso-peptidase, and cleaves ubiquitin from branched poly-ubiquitin chains but not from ubiquitinated substrates. It interacts with another ubiquitin protease and an E3 ubiquitin ligase that inhibits cytokine gene transcription in the immune system. It is proposed to function in specific ubiquitin-dependent pathways, possibly by providing an editing function for polyubiquitin chain growth. Alternative splicing results in multiple transcript variants.
仅用于科研。不用于诊断过程。未经明确授权不得转售。